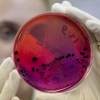

Пакистан
Тревел-блогер Вася Щупальце из Питера на свободе. "Духи" отпустили или "захват" был PR акцией?
Ноябрь 1, 2024 - 09:25 — adminТревел-блогер Вася Щупальце вышел на связь. С ним всё в порядке, он продолжает путешествовать.
За велопутешественника из Питера Васю Щупальце (Игоря Бобко) террористы требуют выкуп в Пакистане
Октябрь 29, 2024 - 10:30 — adminТрэвел-блогера Васю Щупальце похитил «Талибан»*. Блогер снимал видео в районе пакистанского города Дера-Исмаил-хан в зоне племен, а потом связь с ним оборвалась
Пакистан открыл свое воздушное пространство для гражданской авиации
Июль 17, 2019 - 09:41 — adminВоздушное пространство Пакистана снова открыто для рейсов гражданской авиации. Ограничения на полеты были введены пакистанскими властями в конце февраля на фоне эскалации конфликта с Индией.
Португалия: Прекрасные Азорские острова
Июнь 7, 2019 - 12:54 — редакторОпытные путешественники всегда находятся в поисках новых впечатлений и направлений. Одно из самых уникальных мест на Земле, мало знакомое российскому туристу – Азорские острова - способно удивить живописными озерами, древними вулканами, прекрасными водопадами и термальными источниками.
Власти Пакистана смягчили визовый режим
Январь 26, 2019 - 09:20 — редакторВ частности, правительство страны согласовало отмену въездных виз для граждан 50 государств.
Число российских туристов в Японии возросло за три квартала 2018 года на 14 142 человека
Октябрь 17, 2018 - 05:02 — редакторВ сентябре Страну восходящего солнца посетило рекордное количество россиян – 7600 человек. По сравнению с прошлым годом турпоток увеличился на 17,1%.
Роспотребнадзор предупредил туристов о вспышке брюшного тифа в Пакистане
Февраль 25, 2018 - 08:58 — редакторОдин из ведущих ВУЗов Пакистана - Университет Ага-Хан сообщил 23 января 2018 года, что причиной вспышки брюшного тифа в Хайдарабаде (центральный район Пакистана) является загрязнение воды высокоустойчивым штаммом возбудителя этого заболевания.
Об очагах сибирской язвы в Бангладеш, Пакистане и Индии
Июнь 23, 2017 - 10:01 — adminРоспотребнадзор предупредил о вспышках сибирской язвы в Индии, Пакистане и Бангладеш.
Япония: Роскошный круизный поезд «Мидзукадзэ» отправился в первый рейс
Июнь 22, 2017 - 11:07 — редакторНовый роскошный круизный поезд «Твайлайт экспресс Мидзукадзэ» компании JR West отправился из Осаки в свой первый рейс.
Etihad Airways и Pakistan International Airlines заключили код-шеринговое соглашение
Июль 1, 2015 - 02:24 — редакторEtihad Airways и Pakistan International Airlines (PIA) подписали код-шеринговое соглашение, которое обеспечит пассажиров удобными перелетами между Объединенными Арабскими Эмиратами, Пакистаном и другими странами.